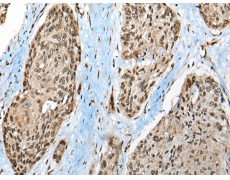
一抗

中文名稱:兔抗CCDC12多克隆抗體
英文名稱: Anti-CCDC12 rabbit polyclonal antibody
別 名: coiled-coil domain containing 12;
相關(guān)類別: 一抗
抗 原: CCDC12
儲 存: 冷凍(-20℃)
宿 主: Rabbit
反應(yīng)種屬: Human, Mouse
標(biāo) 記 物: Unconjugate
克隆類型: rabbit polyclonal
技術(shù)規(guī)格
|
Background: |
CCDC12, also known as FLJ39430, FLJ40801 or MGC23918, is a 166 amino acid protein encoded by a gene mapping to human chromosome 3. Chromosome 3 is made up of about 214 million bases encoding over 1,100 genes. Notably, there is a chemokine receptor gene cluster and a variety of human cancer related loci on chromosome 3. Particular regions of the chromosome 3 short arm are deleted in many types of cancer cells. Key tumor suppressing genes on chromosome 3 encode apoptosis mediator RASSF1, cell migration regulator HYAL1 and angiogenesis suppressor SEMA3B. Marfan Syndrome, porphyria, von Hippel-Lindau syndrome, osteogenesis imperfecta and Charcot-Marie-Tooth Disease are a few of the numerous genetic diseases associated with chromosome 3. |
|
Applications: |
ELISA, IHC |
|
Name of antibody: |
CCDC12 |
|
Immunogen: |
Full length fusion protein |
|
Full name: |
coiled-coil domain containing 12 |
|
SwissProt: |
Q8WUD4 |
|
ELISA Recommended dilution: |
5000-10000 |
|
IHC positive control: |
Human esophagus cancer and human ovarian cancer |
|
IHC Recommend dilution: |
50-300 |


 購物車
購物車 幫助
幫助
 021-54845833/15800441009
021-54845833/15800441009